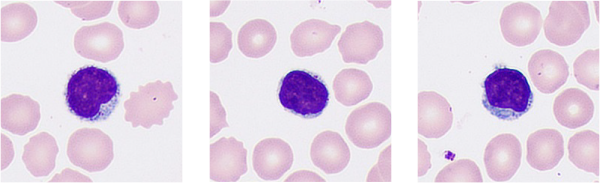
pg电子游戏(试玩)官方网站-APP下载

Dapatkan informasi yang benar tentang morfologi sel
2021-12-27

Banyak laboratorium yang menghadapi kendala seperti proses analisis yang lama dan pemeriksaan mikroskopis yang kurang efisien karena kurangnya tenaga ahli di bidang morfologi sel dan peralatan yang tidak memadai. Kendala ini membuat mereka sulit untuk mencapai tingkat pengujian ulang keseluruhan sebesar 30%, target yang direkomendasikan oleh kelompok konsensus internasional di bidang tinjauan hematologi. Selain itu, kemampuan staf laboratorium bervariasi, menyebabkan adanya inkonsistensi dalam hal standar dan hasil uji laboratorium.
Penganalisis Morfologi Sel Otomatis MC-80 Mindray dirancang untuk menghadirkan analisis morfologi sel yang "Lebih Jelas, Lebih Cerdas, dan Lebih Produktif" untuk analisis morfologi sel, dengan alat bantu cerdas untuk membantu menemukan kebenaran tentang sel.
Mindray berkomitmen untuk meningkatkan efisiensi dan akurasi laboratorium serta telah berkolaborasi dengan para ahli dan ilmuwan di rumah sakit di seluruh dunia sejak tahun 2014. Berdasarkan penelitian intensif, Mindray telah menemukan solusi inovatif dalam bidang pencitraan sel, seperti teknologi fusi Multilapisan, Sistem Antiguncangan Hiperstabil "Solid Rock", Teknologi Mode Terbang, dan banyak lagi.
Lebih Jelas: lebih banyak detail di luar dari penampilan
Sel merupakan unit dasar kehidupan, dan tes morfologi sel merupakan salah satu alat bantu utama untuk mendeteksi penyakit yang ganas. Ahli patologi mempelajari struktur internal dan detail sel untuk berbagai macam kebutuhan.
Saat ini, di sebagian besar laboratorium, ahli morfologi mengamati gambar sel dari setiap sampel pemeriksaan ulang secara manual dengan mikroskop, sehingga hal ini menjadi proses yang berkepanjangan saat volume yang diuji berskala besar.
Untuk mengurangi beban kerja analisis manual dengan mikroskop secara efektif, penganalisis morfologi sel perlu menyimulasikan detail yang ditangkap oleh mikroskop manual sejelas mungkin. Bagaimana pencitraan planar sel bisa mencapai hal ini?
MC-80 secara inovatif menangkap 20 gambar dari setiap sel pada kedalaman bidang yang berbeda.

Inti dari teknologi fusi multikedalaman adalah untuk menciptakan kembali pemfokusan manual yang biasanya dilakukan oleh para dokter dengan menempatkan bagian yang jelas dari 20 gambar. Dalam pencitraan sel dari MC-80, fitur dan detail internal sel normal dan abnormal bisa ditampilkan dengan jelas.




Oleh karena itu, dokter bisa mendapatkan wawasan tentang fitur patologis sel untuk skrining awal kelainan darah dan penyakit menular yang lebih akurat serta menghindari kesalahan deteksi.
Inti dari teknologi fusi multikedalaman adalah untuk menciptakan kembali pemfokusan manual yang biasanya dilakukan oleh para dokter dengan menempatkan bagian yang jelas dari 20 gambar. Dalam pencitraan sel dari MC-80, fitur dan detail internal sel normal dan abnormal bisa ditampilkan dengan jelas.
Oleh karena itu, dokter bisa mendapatkan wawasan tentang fitur patologis sel untuk skrining awal kelainan darah dan penyakit menular yang lebih akurat serta menghindari kesalahan deteksi.
Lebih Cerdas: menghasilkan tampilan sampel secara menyeluruh

Di antara informasi yang kompleks, informasi yang tidak teratur bersifat tidak valid dan menghalangi para dokter untuk menemukan kebenaran informasi.
Mengumpulkan gambar sel merupakan bagian permulaan saja. Dokter perlu mengklasifikasikan setiap sel dengan benar untuk menampilkan hasil sampel secara menyeluruh. Saat melakukan analisis secara manual, proses klasifikasi sering kali dicatat satu per satu oleh dokter. Namun, karena adanya kesamaan pada berbagai jenis sel, dokter hanya bisa mengklasifikasikan sel berdasarkan detail yang ada. Seiring dengan berjalannya waktu, kesalahan bisa terjadi dan memengaruhi akurasi serta efisiensi.
Melalui identifikasi dan praklasifikasi berbagai jenis sel yang andal, MC-80 bisa mencerminkan tampilan sampel secara menyeluruh dengan akurat, sehingga membantu para dokter untuk memahami status pasien.
Pengenalan yang akurat didasarkan pada ekstraksi fitur yang akurat dari gambar digital sel. Dengan bimbingan para ahli bidang morfologi dan patologi di tahap awalnya, tim Mindray mengekstrak informasi mengenai warna, tekstur, dan karakteristik geometris sel pada skala yang berbeda. Dengan meningkatkan tingkat pengenalan sel menggunakan klasifikasi menurun, para ahli patologi bisa mengonfirmasikan jenis sel secara akurat dengan perbandingan kategori dan subkategori.
Tingkatkan laju pengenalan sel menggunakan klasifikasi menurun

MC-80 bisa menyesuaikan mode analisis sebelum dan selama proses dengan cerdas, sesuai dengan informasi dari jalur analisis seluler untuk meningkatkan efisiensi diagnostik.


Untuk penurunan jumlah trombosit yang salah karena penggumpalan, MC-80 dengan FLY-MODE berkecepatan tinggi yang unik bisa memindai tubuh, kedua sisi tubuh, dan bagian ujung apusan dalam jangka waktu satu menit, mengidentifikasi penggumpalan trombosit secara akurat, menghindari proses konfirmasi manual yang memakan waktu lama.
Lebih Produktif: meningkatkan efisiensi analisis morfologi
Hingga saat ini, penangkapan gambar yang jernih dalam tingkat pencahayaan yang stabil membutuhkan waktu paparan yang lama dan kamera tidak boleh bergerak sama sekali. Sepertinya kecepatan dan kejelasan tidak bisa dicapai secara bersamaan.
Hal yang sama berlaku untuk analisis morfologi sel. Selain kejelasan, efisiensi juga bersifat penting untuk menemukan kebenaran informasi secara lebih cepat. Dibutuhkan waktu sekitar 5-8 menit pada setiap sampel untuk melakukan analisis manual tradisional. Di laboratorium berskala besar, beban kerja yang besar membutuhkan personel yang terlatih secara khusus, dan mengakibatkan biaya tenaga kerja yang tinggi.
Laboratorium perlu meninjau sampel dalam jumlah besar.



Pemeriksaan mikroskopis bisa menjadi lebih populer hanya jika hasil ujinya bisa diselesaikan secara lebih cepat. Meningkatkan efisiensi pengujian morfologi sel merupakan tujuan utama dalam mencari kebenaran informasi.
MC-80 menangkap gambar sel dengan tingkat kecepatan tinggi secara konsisten, memproses satu sampel per menit. Melalui pengambilan sampel satu slide yang fleksibel, perangkat ini bisa memberikan hasil yang cepat untuk kasus medis yang bersifat mendesak.
Dibandingkan dengan penganalisis sel tradisional, MC-80 menghadirkan berbagai macam fitur terobosan.

Jumlah gambar yang diambil per jam

MC-80 dilengkapi dengan sistem antiguncangan SOLID ROCK internal yang sangat stabil. Setelah melalui proses verifikasi secara berulang-ulang, bahan kedirgantaraan yang baru bisa menghadirkan kekuatan dan kekakuan yang dibutuhkan MC-80 selama gerakan dengan kecepatan tinggi. Struktur yang stabil dan algoritme paparan berfrekuensi tinggi yang canggih bisa mengatasi gangguan horizontal dan vertikal kecil untuk memastikan adanya hasil analisis sel yang cepat, akurat, dan andal.
Jika terjadi masalah teknis selama pemeriksaan, MC-80 mendukung fitur validasi jarak jauh multiterminal, memungkinkan dilakukannya konsultasi dengan segera.
Tinjauan dan konsultasi jarak jauh di berbagai lokasi

MC-80
Penganalisis Morfologi Sel Digital Otomatis
Lebih Jelas, Lebih Cerdas, Lebih Produktif.
Penganalisis Morfologi Sel Otomatis MC-80 dari Mindray menghadirkan analisis morfologi yang lebih akurat dan andal dengan teknologi terdepan di industrinya. Dengan mengatasi tantangan utama dalam bidang analisis morfologi, Mindray menghadirkan solusi analisis hematologi otomatis secara komprehensif untuk memperkuat tingkat keyakinan, memberikan hasil yang akurat, sekaligus memenuhi tuntutan laboratorium di seluruh dunia yang terkait dengan efisiensi.